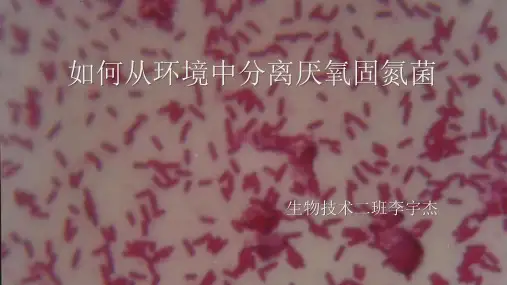

光能/化能自养微生物固定 CO2的主要途径
二、生物固氮
生物固氮作用:将大气中分子态氮<N2>通过微生物固氮酶的 催化而还原成氨<NH3>的过程.生物固氮是地球上仅次于光合 作用的生物化学反应. 〔一〕固氮微生物<nitrogen –fixing organisms ,diazotrophs〕 80余属,全部为原核生物〔包括古生菌〕,主要包括细菌、放线 菌和蓝细菌. 根据固氮微生物与高等植物及其他生物的关系,可将它们分为以 下3类:
转肽酶的转肽作用可被青霉素所抑制. 其作用机制是:青霉素是肽聚糖单体五肽尾 末端的D-丙氨酰—D-丙氨酸的结构类似物,它 们两者可相互竞争转肽酶的活力中心.
1. 代谢是细胞内发生的全部生化反应的总称,主要是由____和 ____两个过程组成.微生物的分解代谢是指____在细胞 内降解成____,并____能量的过程;合成代谢是指利用 ____在细胞内合成____,并____能量的过程.
2. 微生物的4种糖酵解途径中,____是存在于大多数生物体内的 一条主流代谢途径;____是存在于某些缺乏完整EMP途径 的微生物中的一种替代途径,为微生物所特有;____是产生4 碳、5碳等中间产物,为生物合成提供多种前体物质的途径.
UDP
UDP G
G M P P 类脂
M P P 类脂
G M P P 类脂
UMP UDP M
P
类 脂
P P 类脂
杆菌肽
万古霉素
〔三〕在细胞膜外的合成
从焦磷酸类脂 载体上卸下来 的肽聚糖单体, 会被运送到 细胞膜外正在 活跃合成肽聚 糖的部位. 原有肽聚糖分 子成了新合成 分子的引物.
在细胞膜外合成 肽聚糖时的转糖基 作用和转肽作用